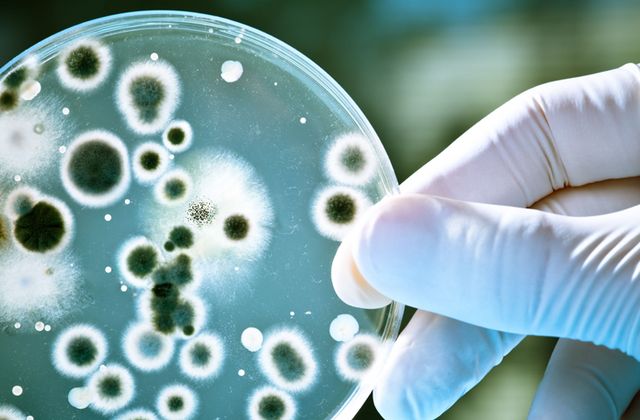

OUR SPECIAL SERVICES
CLINICAL RESEARCH SERVICES
Our core competency, project management is underpinned by comprehensive and consistent processes, which conform to global regulatory requirements.
MEDICAL SERVICES AND REGULATORY AFFAIRS
Regulatory authorities has a clinical trials of both non-registered statutory obligation to ensure that the drugs available in the country fulfils the necessary requirements for safety, quality and efficacy.

CONSULTANCY AND RESEARCH TRAINING SERVICES
We provide a comprehensive guide to the basic principles, regulations and guidelines of ICH Good Clinical Practice, for conducting clinical trials and researches.

